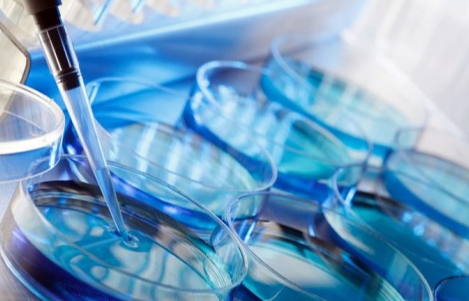

供卵试管技术为许多因卵巢功能衰退或其他原因无法使用自身卵子的女性提供了生育希望。2025年,上海地区的供卵试管技术进一步发展,多家医院在这一领域表现出色。本文将从医院推荐、如何选择合适的供卵试管医院以及供卵试管的注意事项等方面为您全面解析,帮助您做出更加合适的选择。
2025年上海供卵试管医院推荐
以下是2025年上海地区供卵试管医院的推荐榜单,包含成功率、大致费用及优势:
| 医院名称 | 成功率 | 大致费用(元) | 优势 |
|---|---|---|---|
| 上海交通大学医学院附属瑞金医院 | 65%-75% | 12万-18万 | 专业团队、先进设备、高成功率,提供个性化服务。 |
| 复旦大学附属妇产科医院 | 60%-70% | 10万-15万 | 历史悠久,技术成熟,医生经验丰富,费用相对合理。 |
| 上海集爱遗传与不育诊疗中心 | 55%-65% | 15万-20万 | 专注于辅助生殖技术,服务优质,适合高需求患者。 |
| 上海市第一妇婴保健院 | 50%-60% | 8万-12万 | 公立医院,费用较低,适合预算有限的患者。 |
| 上海长征医院 | 50%-60% | 10万-14万 | 综合性医院,设备齐全,服务周到,性价比高。 |
如何选择一家合适的供卵试管医院
选择合适的供卵试管医院是成功的关键,以下是一些选择建议:
1、医院资质和口碑:选择有正规资质、口碑良好的医院,确保医疗质量和安全性。
2.医生团队和经验:了解医院的医生团队背景和经验,选择有丰富供卵试管经验的医生。
3.成功率和案例:参考医院的成功率和实际案例,选择成功率较高的医院。
4.设备和技术:先进的设备和技术是成功率的保障,选择设备齐全、技术先进的医院。
5.服务质量和环境:优质的服务和舒适的环境有助于减轻患者的心理压力,提高成功率。
6.费用透明度:选择费用透明、无隐性收费的医院,避免经济负担过重。

供卵试管的注意事项
供卵试管治疗过程中需要注意以下事项:
(一)治疗前注意事项
1.全面身体检查:包括激素水平检测、子宫内膜检查等,确保身体状况适合供卵试管治疗。
2.心理准备:供卵试管治疗过程较长,患者需保持乐观心态,避免过度焦虑。
3.选择合适的供卵者:根据医生建议选择合适的供卵者,确保卵子质量。
(二)治疗中注意事项
1.遵医嘱用药:严格按照医生的建议服用药物,避免擅自停药或更改剂量。
2.定期检查:按时进行术后检查,监测胚胎着床情况和身体恢复状况。
3.避免剧烈运动:移植后避免剧烈运动和重体力劳动,保持适当休息。
(三)治疗后注意事项
1.注意饮食:多摄入富含营养的食物,避免辛辣刺激性食物。
2.保持良好:心态移植后保持乐观心态,避免过度紧张和焦虑。
3.定期复查:按时进行复查,确保胚胎发育正常。

总结:2025年,上海地区的供卵试管技术进一步发展,多家医院提供高成功率的服务。上海交通大学医学院附属瑞金医院以65%-75%的成功率位居榜首,是供卵试管技术的首选。如果您有相关需求,建议选择正规医院,提前做好身体调理,并通过科学方法提高成功率。如果您还有疑问,也可以咨询百禾孕育助孕中心,我们的专业团队将竭诚为您服务,祝您早日完成生育大计!
